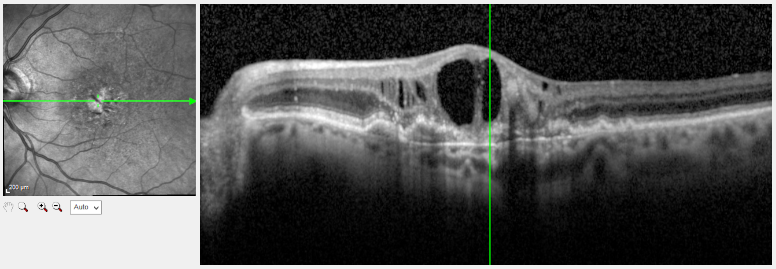

In der Regel bemerkt man in der Frühphase die Erkrankung nicht. Erste subjektiv spürbare Anzeichen können sein: Beim Lesen bemerkt man ein Fehlen oder „Tanzen“ von Buchstaben oder ein allgemeines verschwommenes Sehen. Gerade Linien können verzerrt oder wellig erscheinen. Später taucht in der Mitte des Sehfeldes ein zunehmend verzerrter unscharfer Fleck auf, der sich mit der Zeit immer weiter vergrößert. Das bedeutet, dass man beispielsweise eine Uhr sehen, die Uhrzeit aber nicht erkennen kann. Farben wirken verschwommen, gerade Linien scheinen verbogen. Vor wenigen Jahren galt die Erkrankung als unheilbar, heutzutage existieren sehr wirksame Therapiemöglichkeiten, auch schon in der Frühphase. Deshalb empfehlen Augenärzte ab dem 60. Lebensjahre eine regelmäßige Makulavorsorge (AMD-Vorsorge).
Makuladegeneration (AMD)
Die altersbedingte Makuladegeneration ist eine der häufigsten Erblindungsursachen in höherem Lebensalter. Es gibt selten auch ererbte Formen einer Makuladegeneration, die in Jugend oder jungem Erwachsenenalter auftreten können.
Altersabhängige trockene Makuladegeneration
Von der trockenen Form sind ca. 85 Prozent aller unter AMD-Leidenden betroffen. Dabei bildet sich ein Teil der Netzhaut zurück, wird dünner und kann absterben. Eine Vorstufe können Ablagerungen unter der Netzhaut, sog. Drusen, sein. Die Sehfähigkeit wird durch den Ausfall von Sehzellen schrittweise beeinträchtigt. Zu Beginn einer AMD ist die Sehkraft zunächst nur wenig eingeschränkt. Im fortgeschrittenen Verlauf der Erkrankung wird die zentrale Sehschärfe mit dem zentralen Gesichtsfeld jedoch erheblich beeinträchtigt oder fällt vollständig aus.
Altersabhängige feuchte Makuladegeneration
Die feuchte Form der AMD entwickelt sich in der Regel aus der trockenen AMD und ist schneller fortschreitend. Bei dieser Form wachsen neue, poröse Blutgefäße aus der Aderhaut unter und in die Netzhaut und lösen Blutungen, Schwellungen und in späten Stadien auch Narbenbildungen aus. Dies kann zu schweren Einschränkungen der Nah- und Weitsicht führen, so dass zum Beispiel Gesichter nicht mehr erkannt werden und alltägliche Handlungen, wie Lesen und Autofahren nicht möglich sind. Diese Form ist zwar seltener, jedoch geht sie mit einem schnell fortschreitenden und irreversiblen Sehverlust einher.
Eine Heilung der Erkrankung ist bis heute nicht möglich. In vielen Fällen ist es bei der feuchten AMD aber heute durch eine Therapie möglich, das Fortschreiten zu stoppen oder zu verlangsamen. In erster Linie kann dies durch die regelmäßige Injektion eines hochwirksamen Medikamentes (Anti VEGF) erreicht werden, in selteneren Fällen auch durch die photodynamische Therapie (PDT), eine gezielte Laserkoagulation oder eine Operation.
Vorbeugung und Erhalt des Lesens
Da zerstörte Sehzellen nicht ersetzt werden können, ermöglicht nur eine frühzeitige Diagnose, rechtzeitig Gegenmaßnahmen einzuleiten. Da die trockene Form in die feuchte Form übergehen kann, ist einerseits eine regelmäßige Netzhautuntersuchung ab dem 60. Lebensjahr durch den Augenarzt wichtig. Andererseits müssen Warnzeichen wie verzerrtes oder schlechter werdendes zentrales Sehen (siehe Test mit dem Amslergitter) innerhalb weniger Tage augenärztlich abgeklärt werden. Zusätzlich ist eine gesunde Ernährung hilfreich, in der viele Vitamine und insbesondere das zum Oxidationsschutz der Macula wichtige Lutein enthalten sind oder eine gezielte Nahrungsergänzung mit diesen Schutzstoffen für die Macula. Das Rauchen sollte möglichst vermieden werden.
Wenn die Erkrankung soweit fortgeschritten ist, dass ein normales Lesen mit der Lesebrille nicht mehr oder nur noch mit Anstrengung möglich ist, so können vergrößernde Sehhilfen weiter helfen: Neben einem guten Licht sind dies Lupen, Lupenbrillen, oder elektronische Hilfsmittel wie elektronische Lupen, die eine noch stärkere Vergrößerung bieten oder elektronische Lesegeräte bis hin zu Vorlesegeräten. Auch zahlreiche andere Hilfsmittel können das Leben einer sehbehinderten Person erleichtern.
Weitere Informationen erhalten Sie gern in unserer Praxis.
Beispiel einer feuchten Makuladegeneration in der OCT Messung mit einem genauen Querschnitt
durch die Netzhaut. Man erkennt die großen schwarzen Flüssigkeits-Zysten, die hier nicht
hingehören.
Beispiel einer feuchten Makuladegeneration in der OCT Messung mit einem genauen Querschnitt
durch die Netzhaut. Man erkennt die großen schwarzen Flüssigkeits-Zysten, die hier nicht
hingehören.

